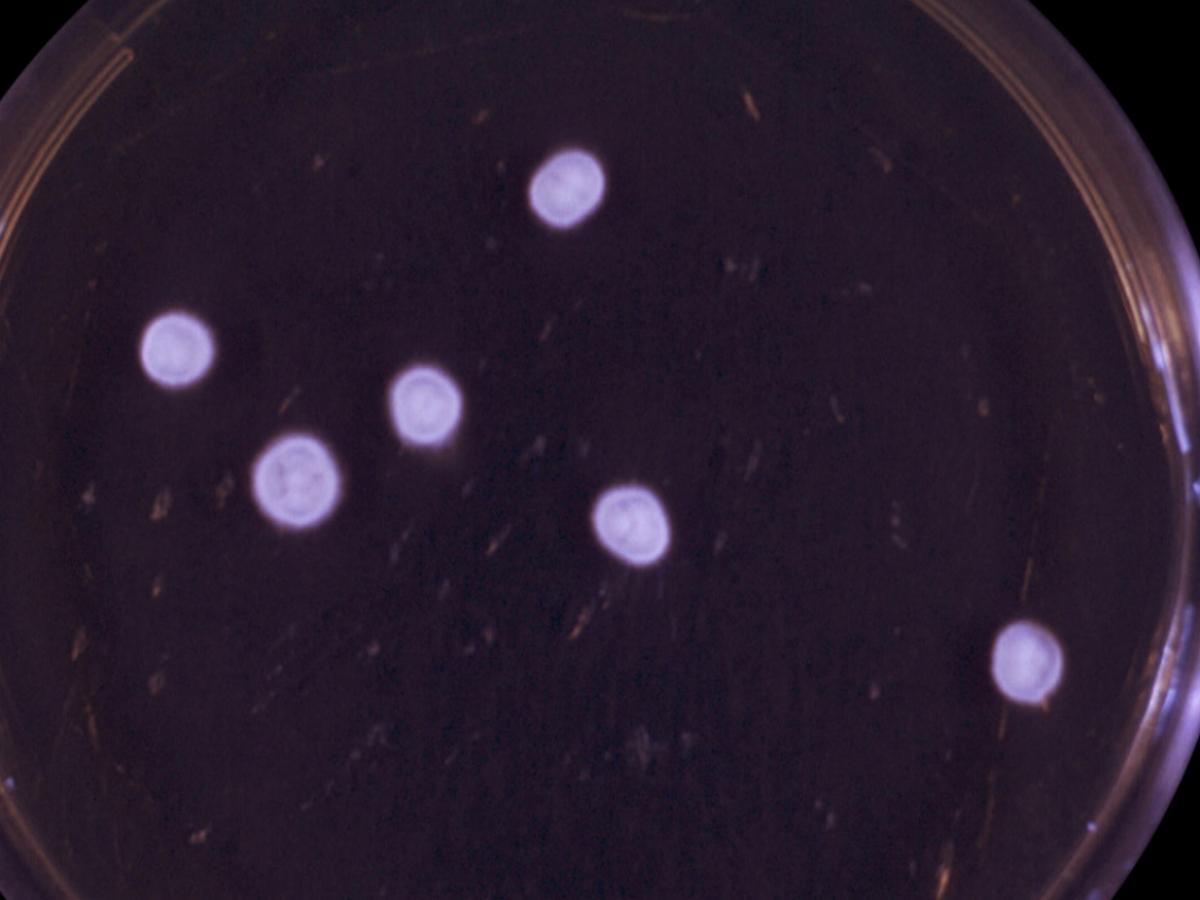
Culture

Status message
Correct! Excellent, you have really done well. Please find additional information below.
Unknown 38 = Trichophyton verrucosum
Clinical presentation:

Culture: On Sabouraud's dextrose agar, colonies are slow growing, small, button-or-disk-shaped, white to cream coloured, with a suede-like to velvety surface, a raised centre, and flat periphery with some submerged growth. Reverse pigment may vary from non-pigmented to yellow.
Microscopy: Microscopic examination of young 4 to 5 day old colonies, grown from a very small inoculum, on Sabouraud's' dextrose agar containing 0.5% yeast extract and incubated at 30C, show characteristic terminal vesicles (not chlamydoconidia) at the tips of hyphae. The number of vesicles produced is greater from primary inoculations of skin scrapings or hairs.
Microscopy usually shows broad, irregular hyphae with many terminal and intercalary chlamydospores. Chlamydospores are often in chains. The tips of some hyphae are broad and club-shaped, and occasionally divided, giving the so-called "antler" effect. When grown on thiamine-enriched media, occasional strains produce clavate to pyriform microconidia borne singly along the hyphae. Macroconidia are only rarely produced, but when present have a characteristic tail or string bean shape.

Clavate to pyriform microconidia of T. verrucosum.

Characteristic rat tail or string bean shaped macroconidia of T. verrucosum.

All strains produce typical chains of chlamydoconidia, often referred to as "chains of pearls", when grown in brain heart infusion broth containing para-aminobenzoic acid (P.A.B.) and agar at 37C.

Comment: Trichophyton verrucosum is a zoophilic fungus causing ringworm in cattle. Infections in humans result from direct contact with cattle or infected fomites and are usually highly inflammatory involving the scalp, beard or exposed areas of the body (ie. nails, skin). Invaded hairs show an ectothrix infection and fluorescence under Wood' ultra-violet light has been noted in cattle but not in humans. Geographic distribution is world-wide.
About Trichophyton Back to virtual assessment